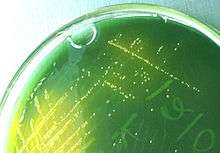

Thiosulfate-citrate-bile salts-sucrose agar
Thiosulfate-citrate-bile salts-sucrose agar, or TCBS agar, is a type of selective agar culture plate that is used in microbiology laboratories to isolate Vibrio spp.[1] TCBS agar is highly selective for the isolation of V. cholerae and V. parahaemolyticus as well as other vibrios. TCBS agar contains high concentrations of sodium thiosulfate and sodium citrate to inhibit the growth of Enterobacteriaceae. Inhibition of Gram-positive bacteria is achieved by the incorporation of ox gall, which is a naturally occurring substance containing a mixture of bile salts and sodium cholate, a pure bile salt. Sodium thiosulfate also serves as a sulfur source and its presence, in combination with ferric citrate, allows for the easy detection of hydrogen sulfide production. Saccharose (sucrose) is included as a fermentable carbohydrate for metabolism by Vibrio species. The alkaline pH of the medium enhances the recovery of V. cholerae and inhibits the growth of others. Thymol blue and bromothymol blue are included as indicators of pH changes.[2]
Formula
- Approximate amounts per liter[3]
- Yeast extract 5.0 g
- Proteose Peptone 10.0 g
- Sodium thiosulfate 10.0 g
- Sodium citrate 10.0 g
- Ox gall 5.0 g
- Sodium cholate 3.0 g
- Saccharose 20.0 g
- Sodium chloride 10.0 g
- Ferric citrate 1.0 g
- Bromothymol blue 0.04 g
- Thymol blue 0.04 g
- Agar 15.0 g
Expected results
- V. cholerae ............................ Large yellow colonies.
- V. parahaemolyticus .............. Colonies with blue to green centers.
- V. alginolyticus ....................... Large yellow mucoidal colonies.
- V. harveyi / V. fischeri..............Greyish-green to bluish-green colonies which show luminescence in dark. Older colonies fail to show bioluminescence.
- Proteus/Enterococci .............. Partial inhibition. If growth, colonies are small and yellow to translucent.
- Pseudomonas/Aeromonas .... Partial inhibition. If growth, colonies are blue.
Bacteria that are not Vibrio but produce hydrogen sulfide grow as small black colonies. This is because the hydrogen sulphide produced from thiosulphate, which acts as a source of sulphur and creates a reduced oxygen tension in which Vibrio can grow due to its facultative anaerobic nature, combines with ferric ions from ferric citrate to produce ferric sulphide, which is black.
TCBS agar is both selective and differential. It is highly selective for Vibrio species and differential due to the presence of sucrose and the dyes. Sucrose fermentation produces acid, which converts the colour of bromothymol blue or thymol blue. Two dyes rather than one make the medium produce an array of yellow, green, or blue so that differentiating among various Vibrio species is possible.
Control of Acanthaster planci
TCBS agar has also been used to control outbreaks of the crown-of-thorns sea star (Acanthaster planci), which is a threat to coral reefs. Single injections lead to deaths of sea stars within 24 hours, with symptoms of "discolored and necrotic skin, ulcerations, loss of body turgor, accumulation of colourless mucus on many spines especially at their tip, and loss of spines. Blisters on the dorsal integument broke through the skin surface and resulted in large, open sores that exposed the internal organs." This was due to promotion of the growth of naturally occurring Vibrio species to high densities, with subsequent symbiont imbalance.[5]
References
- ↑ Pfeffer, C.; Oliver, J.D. (2003). "A comparison of thiosulphate-citrate-bile salts-sucrose (TCBS) agar and thiosulphate-chloride-iodide (TCI) agar for the isolation of Vibrio species from estuarine environments". Letters in Applied Microbiology. 36 (3): 150–151. doi:10.1046/j.1472-765X.2003.01280.x. PMID 12581373.
- 1 2 "Application TCBS Agar (Vibrio Selective Agar)". web site of Merck KGaA. Retrieved 2013-03-18.
- ↑ Kobayahsi, T.; Enomoto, S.; Sakazaki, R.; Kuwahara, S. (November 1963). "A New Selective Isolation Medium for the Vibrio Group; On a Modified Nakanishi's Medium (TCBS Agar Medium)". Nippon Saikingaku Zasshi (Japanese Journal of Bacteriology) (in Japanese). 18: 387–392. PMID 14115910 – via http://catalog.hardydiagnostics.com/cp_prod/Content/hugo/TCBSAgar.htm.
- ↑ Charles A. Kaysner; Angelo DePaola, Jr. "Bacteriological Analytical Manual, Chapter 9: Vibrio". Food and Drug Administration. Retrieved 2013-03-18.
- ↑ http://www.int-res.com/articles/dao_oa/d097p085.pdf.